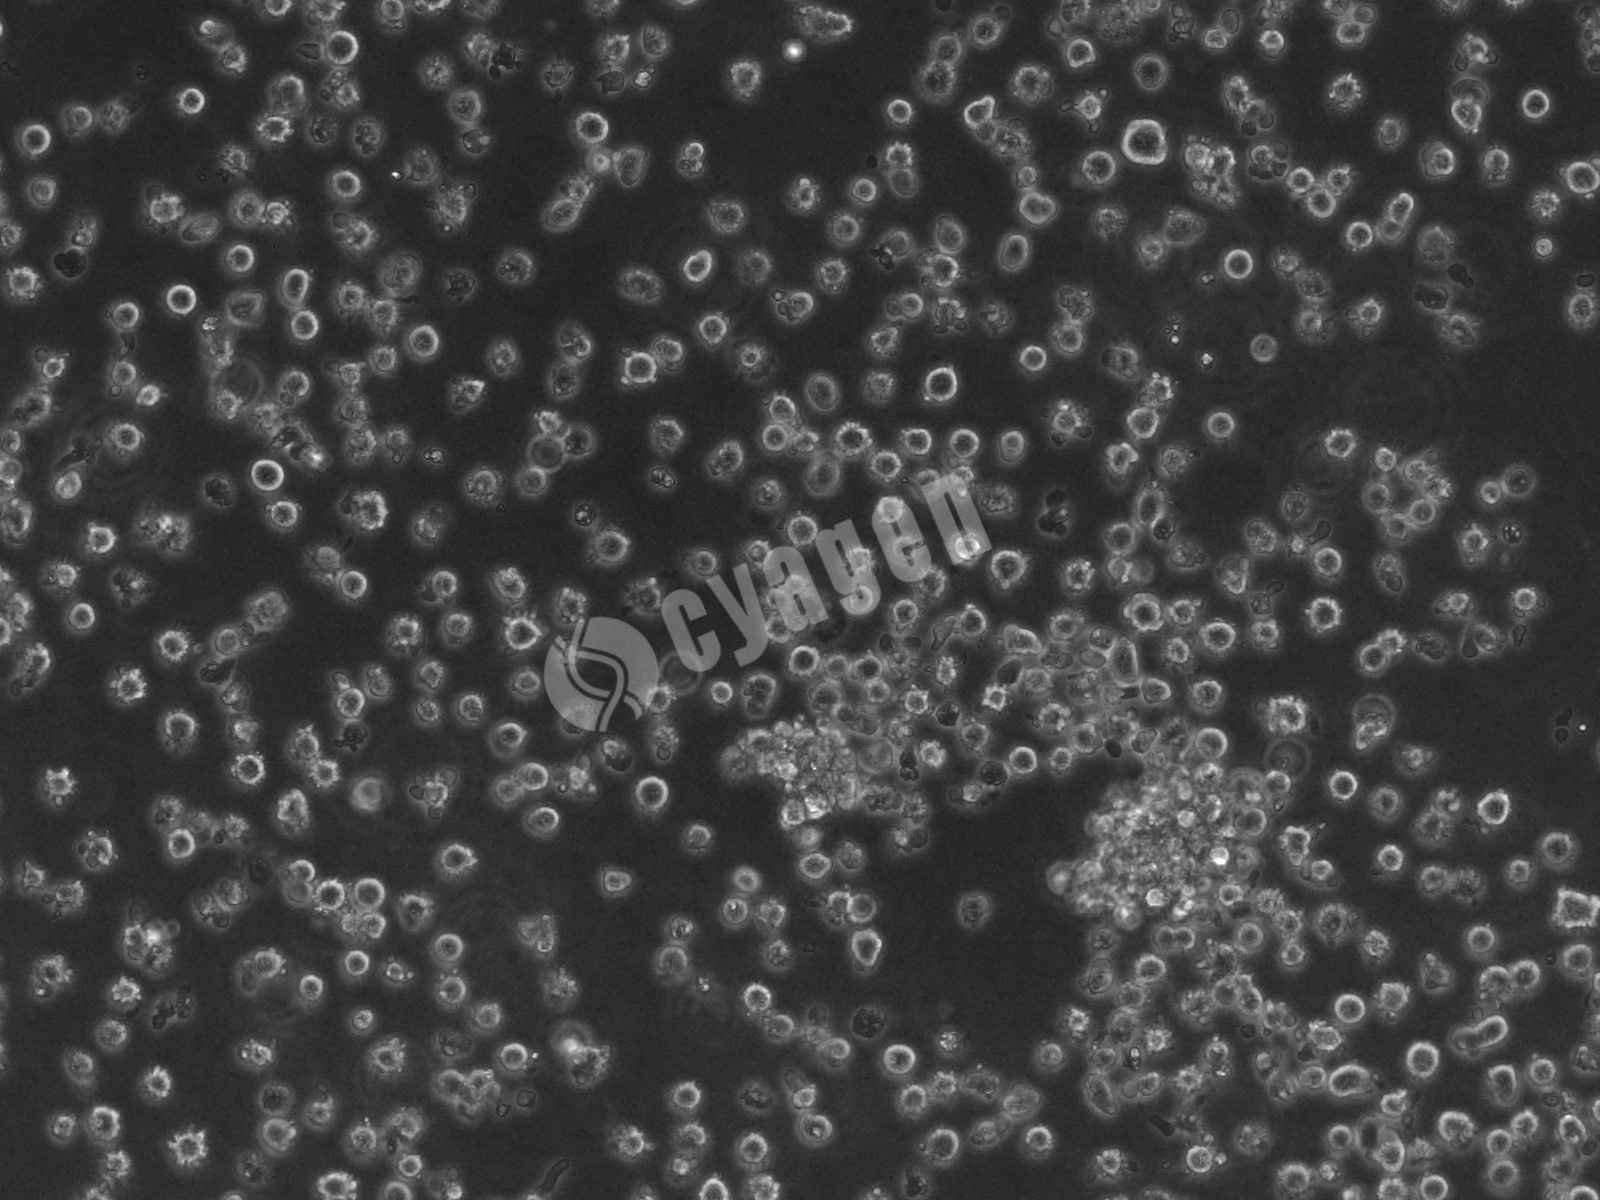
iPSC-HPC（造血祖细胞）

iPSC-CN(皮质神经元)
细胞基本信息:
|
产品名称 |
iPSC-CN(皮质神经元) |
|
服务编号 |
SY-iCN-00001 |
|
来源 |
iPSC(成纤维细胞) |
|
基因型 |
WT |
|
应用 |
阿尔茨海默病(AD) |
|
培养体系 |
iPSC-CN成熟培养基套装 |
|
培养条件 |
95% 空气;5% CO2;37℃ |
|
产品状态 |
对数生长期 ;神经细胞样;轴突萌发 |
|
规格 |
1×106个/管 |
|
保存条件 |
液氮(-196℃) |
注意:本产品在生产过程中严格控制无菌,后续培养过程请根据实际情况是否添加抗生素。
产品制备流程和明场图:




处理原则:
1. 本产品仅供科研使用,不得用于临床治疗、诊断或其他非科研用途。
2. 在操作本产品前,操作人员应具备相应的细胞培养技能和生物安全防护知识,严格遵守生物安全操作规程,穿戴好无菌手套、口罩、防护服等防护用品,在超净工作台中进行无菌操作,避免细胞受到污染。
3. 冻存管从液氮或 - 80℃冰箱中取出后,应迅速解冻,避免细胞在解冻过程中受到损伤;解冻后的细胞应尽快进行复苏和培养,不宜长时间放置。
4. 细胞培养过程中,应严格控制培养条件(如温度、CO2 浓度、pH 值等),保持培养环境的稳定;培养基应在有效期内使用,使用前应检查培养基是否有浑浊、变色、沉淀等异常现象,若有异常,不得使用。
5. 在进行细胞传代、冻存等操作时,应避免过度消化或用力吹打细胞,以免损伤细胞;传代比例应根据细胞的生长速度和特性进行适当调整。
6. 本产品应按照规定的储存条件进行储存和运输,在储存和运输过程中,应定期检查储存设备和运输箱的温度,确保温度符合要求;若发现储存设备或运输箱出现故障,应及时采取措施,避免影响细胞质量。
7. 每批产品的质量控制报告应妥善保存,以备查阅;若在使用过程中发现产品质量问题,应及时与生产厂家联系,以便及时处理。
填写需求描述给我们
工具快速咨询
400-680-8038
info@oricellbio.cn